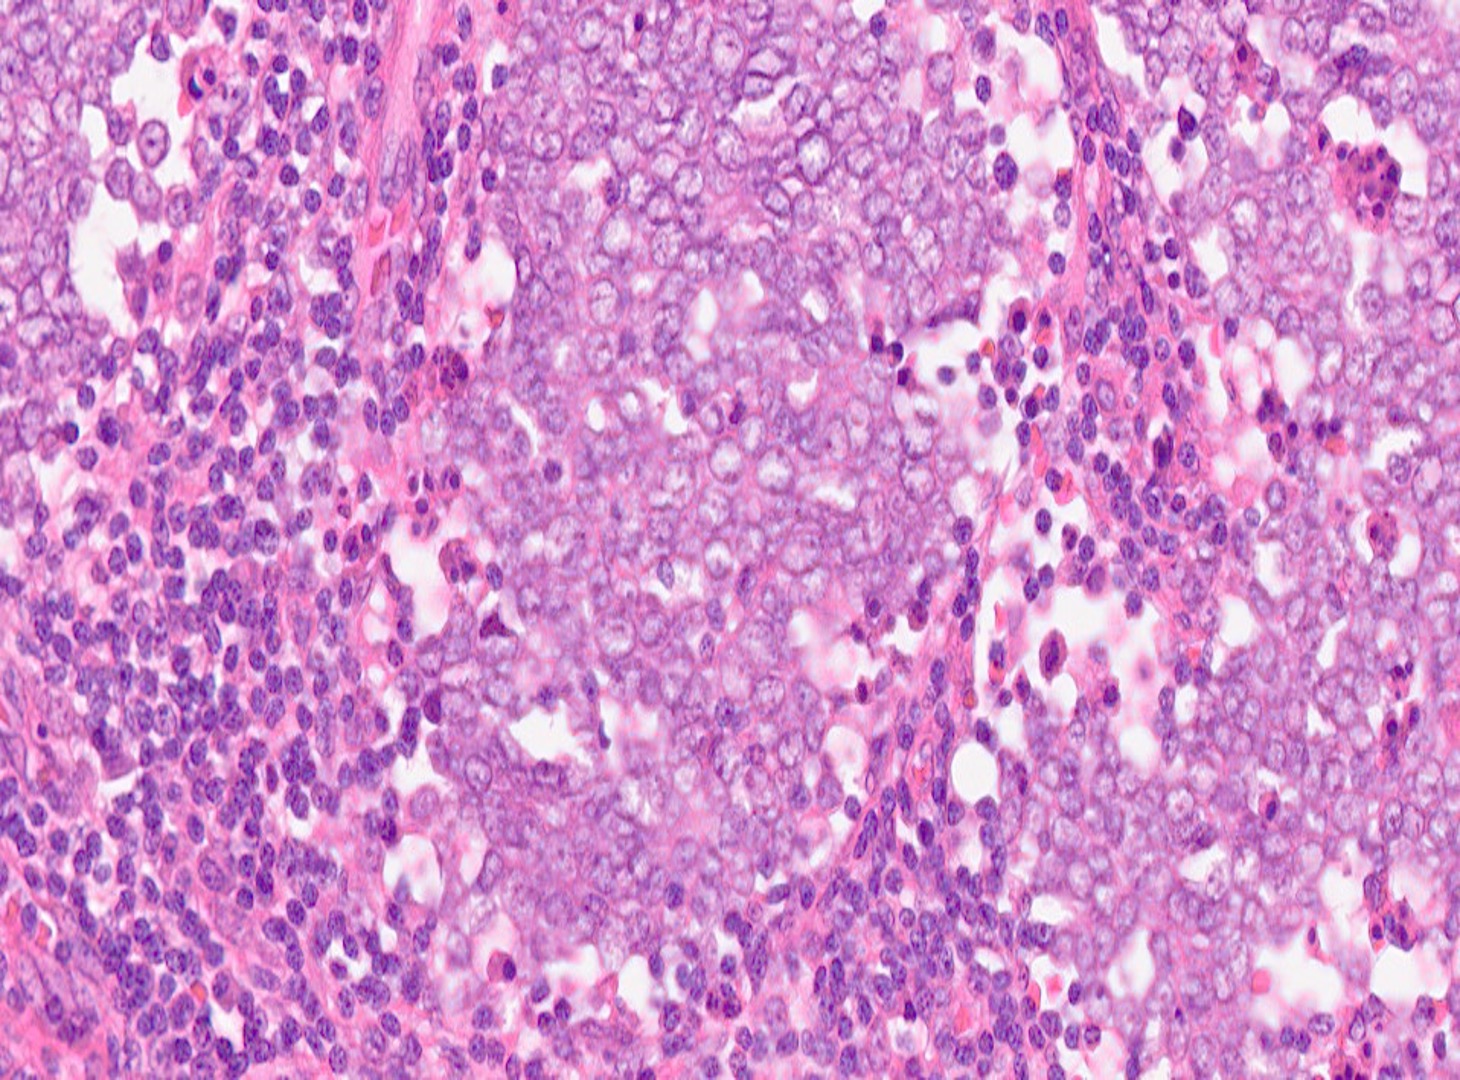

Case Study #8
March 2026 - 66-year-old patient
A 66-year-old patient in Fort Lauderdale, FL, was admitted with a rapidly growing, painless purplish-nodule on the left cheek. Initially thought to be a cyst, the lesion has tripled in size within three months. The patient has fair skin with a history of sunburns and a basal cell carcinoma that was removed from the ear 2 years prior. The only additional notable medical history was a kidney transplant 10 years prior.
Clinical examination confirmed a 2 cm, firm, non-tender, red-purple nodule on the left cheek. The dermoscopic examination indicated that the lesion displays irregular vascular patterns with no clear pigment network.
A full-thickness biopsy of the lesion was taken.
What is the diagnosis?

H&Ex10

H&Ex20
H&Ex40

HHV-8x20

PRAMEx20

SOX-10x20

Cytokeratin 8 & 18 x20

CK20x20

Synaptophysinx20

CD56x20

Chromogranin Ax20

INSM1x20

 Dermatopathology
Dermatopathology